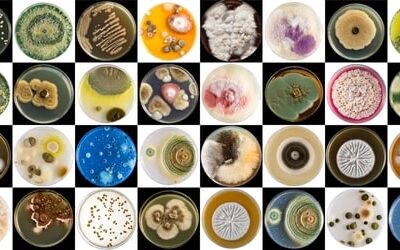

Informative Posts Written by the Experts at Car Mold Guys
Interactive Sunroof Water Leak Guide
Interactive Sunroof Water Leak Guide | Car Mold Guys Car Mold Guys Symptoms Causes Solutions Get Professional Help Symptoms Causes Solutions Get Help Expert Diagnosis for Sunroof Water Leaks Protect your vehicle from water stains, electrical damage, and hazardous mold...
Detecting mold in a car
Detecting car mold is essential to prevent it from spreading and causing harm. Mold can grow in any part of the car, including the carpet, seats, air conditioning ducts, and even the dashboard. It thrives in moist environments, making it important to keep your car dry...
Stachybotrys – Black mold
Stachybotrys black mold is a genus of molds, commonly known as "black mold" or "toxic black mold" due to the dark greenish-black color of some species. These molds are filamentous fungi that can produce mycotoxins, which can be harmful to humans and animals if...
Is All Black Mold Toxic?
Is All Black Mold Toxic? When people hear the term “black mold,” alarm bells often ring. Images of health hazards and home invasions by this notorious fungus may come to mind. However, the truth about black mold is more nuanced. Not all black mold is toxic, and...
The Latest Medical Treatments for Mold Exposure
The Latest Medical Treatments for Mold Exposure Mold exposure has become a growing concern due to its link to respiratory issues, allergic reactions, and more severe health problems. Advances in medical research and treatment protocols have provided new ways to...
What Are Common Organic Materials Found in Cars?
What Are Common Organic Materials Found in Cars? Cars are marvels of engineering, designed for performance, comfort, and aesthetics. While metals, plastics, and synthetic materials form the backbone of automotive construction, organic materials also play a significant...
Is Car Mold a Common Problem?
Is Car Mold a Common Problem? When we think about maintaining our vehicles, mold growth may not immediately come to mind. However, mold in cars is a surprisingly common issue, and it can lead to unpleasant odors, health concerns, and potential damage to the interior....
Protective Gear for Mold Remediation
Protective Gear for Mold Remediation Mold remediation is a critical process for restoring healthy living and working environments. However, dealing with mold is not without risks. Mold spores can pose serious health hazards, including respiratory issues, skin...
How Vast is the Mold World
The Vast Mold World Mold is a fascinating and diverse group of fungi that plays an essential role in ecosystems around the world. These organisms are not only responsible for breaking down organic matter but can also impact human health and infrastructure. But just...
How Mold Spreads in a Car
How Mold Spreads in a Car Mold is a common and often underestimated problem for car owners. Once it takes hold, it can spread quickly, leading to health risks and damage to your vehicle’s interior. Understanding how mold spreads in a car can help you take preventive...
The History of Mold and Health
The History of Mold and Health Mold, a ubiquitous organism belonging to the fungi kingdom, has been a part of Earth’s ecosystem for millions of years. Its history is intricately tied to the development of life on our planet, and its health implications have been...
Why Wet Moldy Car Carpet Padding Produces an Unbearable Odor
Photo of wet moldy carpet padding
Is CLO2 Superior to Ozone for Mold Remediation
Is CLO2 Superior to Ozone for Mold Remediation? Chlorine dioxide (ClO2) is often considered superior to ozone for mold remediation because it is more effective at penetrating porous materials to reach deep-seated mold spores, can kill a wider range of mold species,...
Best Practices for Drying Out a Wet Car
Best practices for drying out a wet car
How does mold grow on inorganic surfaces
Mold typically requires specific conditions to grow, even on inorganic surfaces. While mold itself cannot directly metabolize inorganic materials, it can thrive on these surfaces if they provide the right environment and nutrients. Here's how mold grows on inorganic...